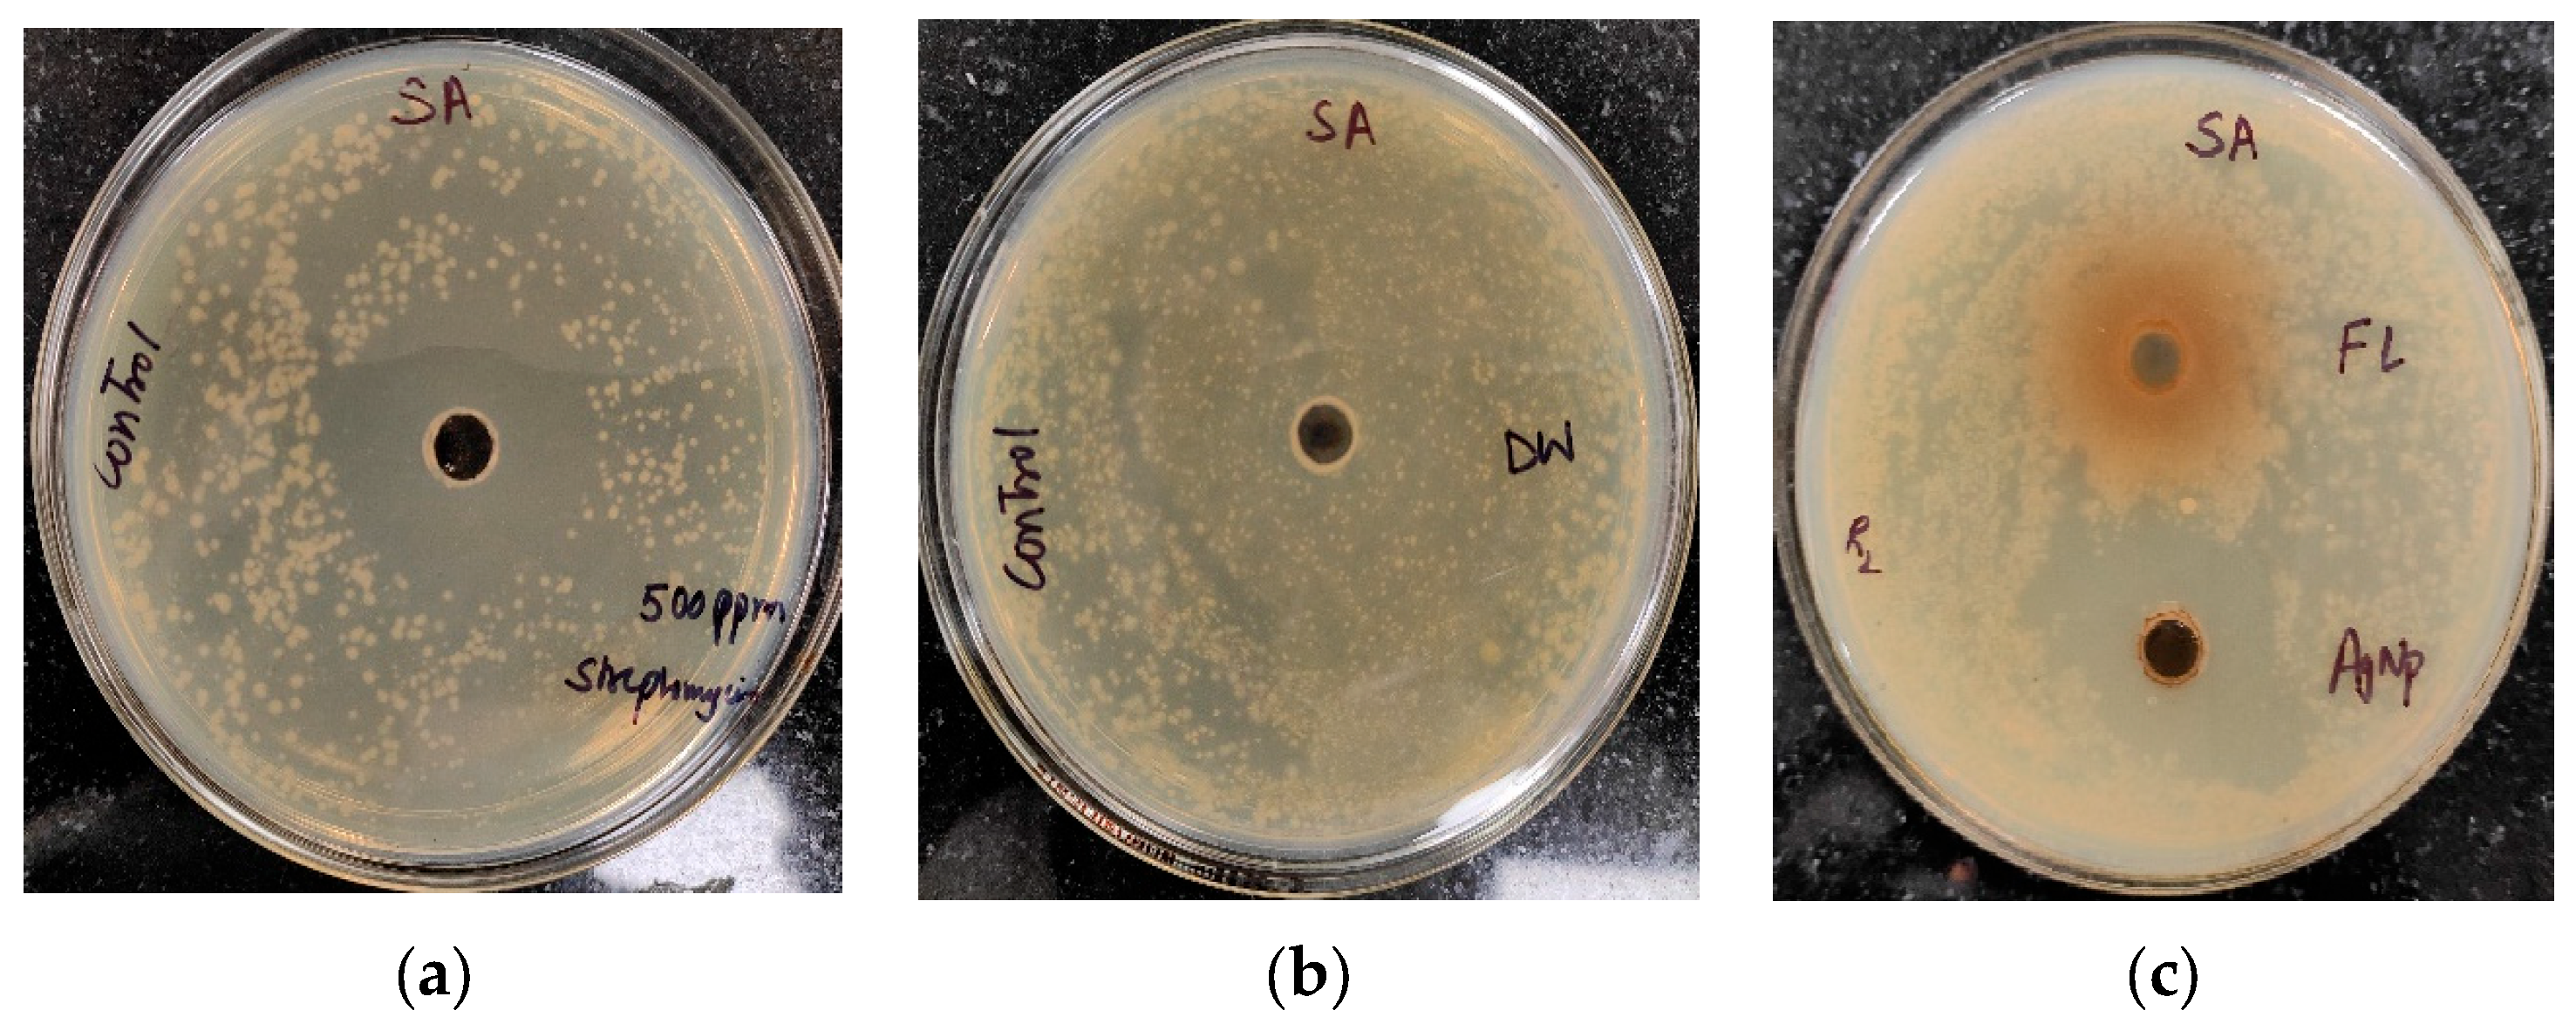
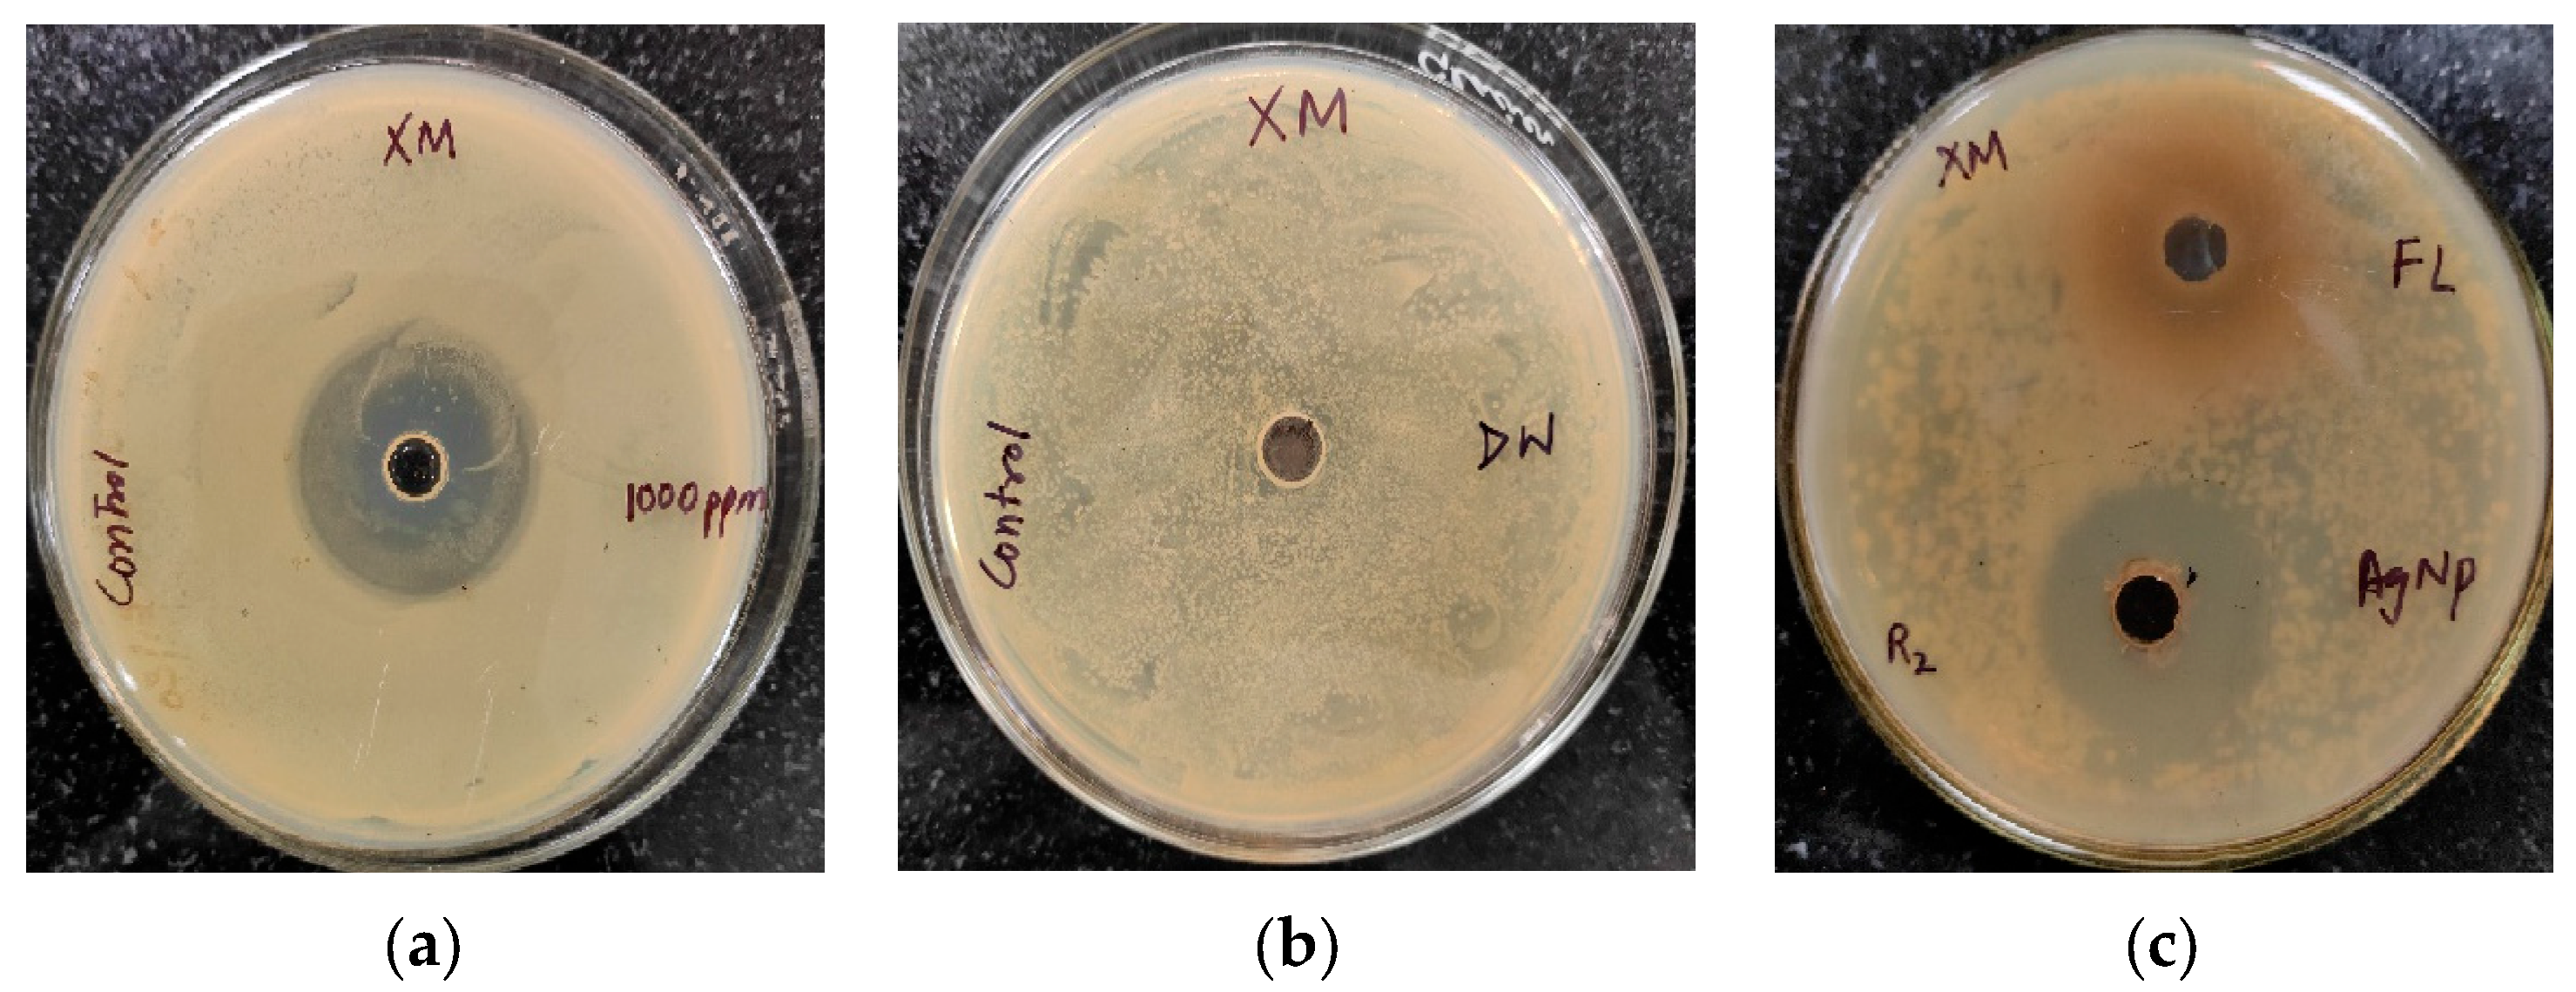
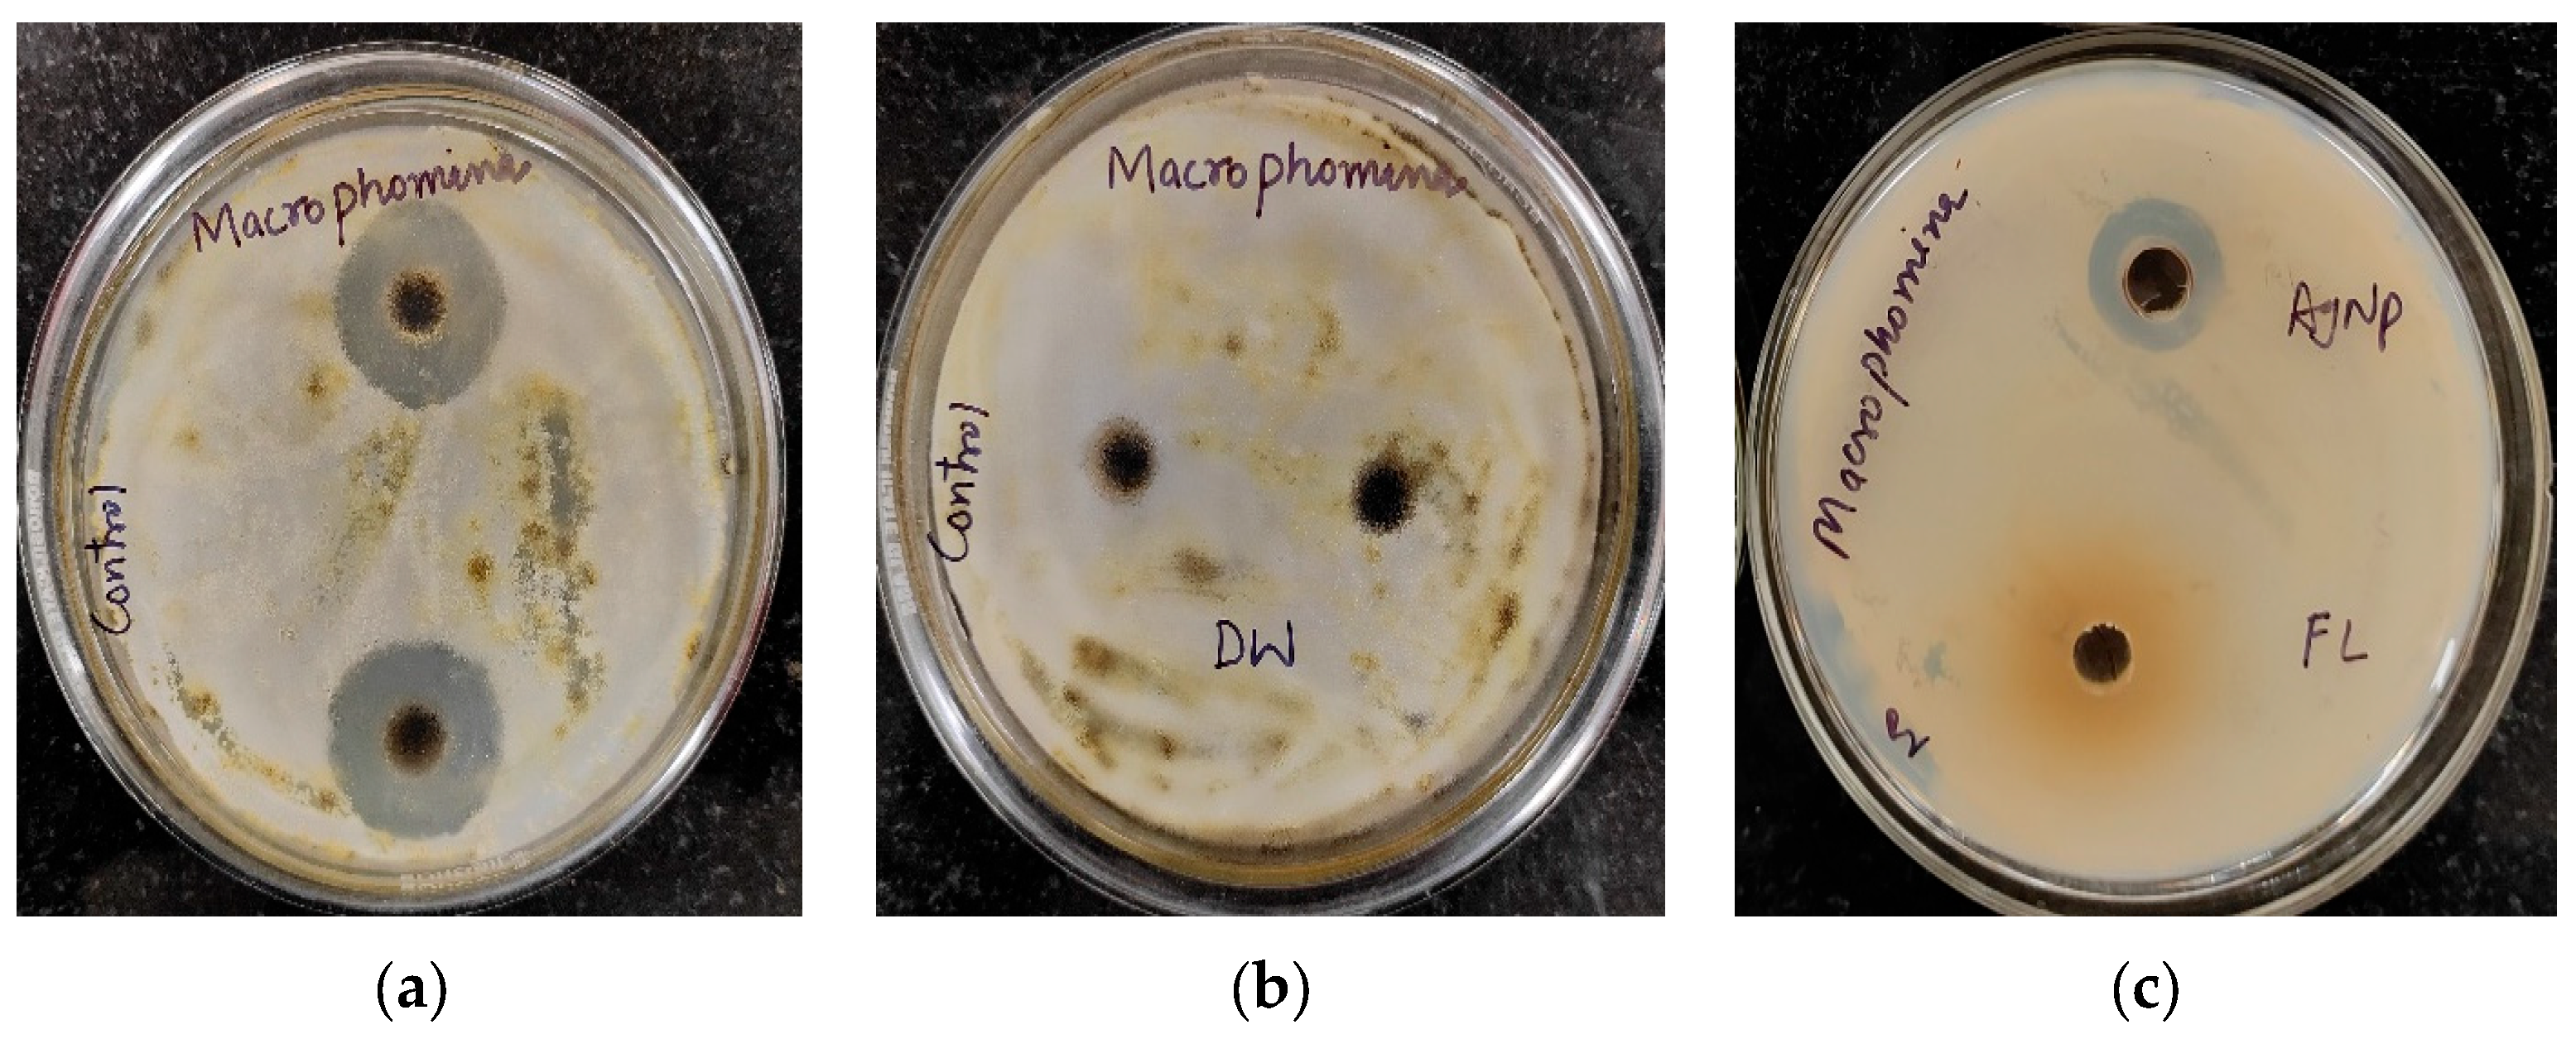
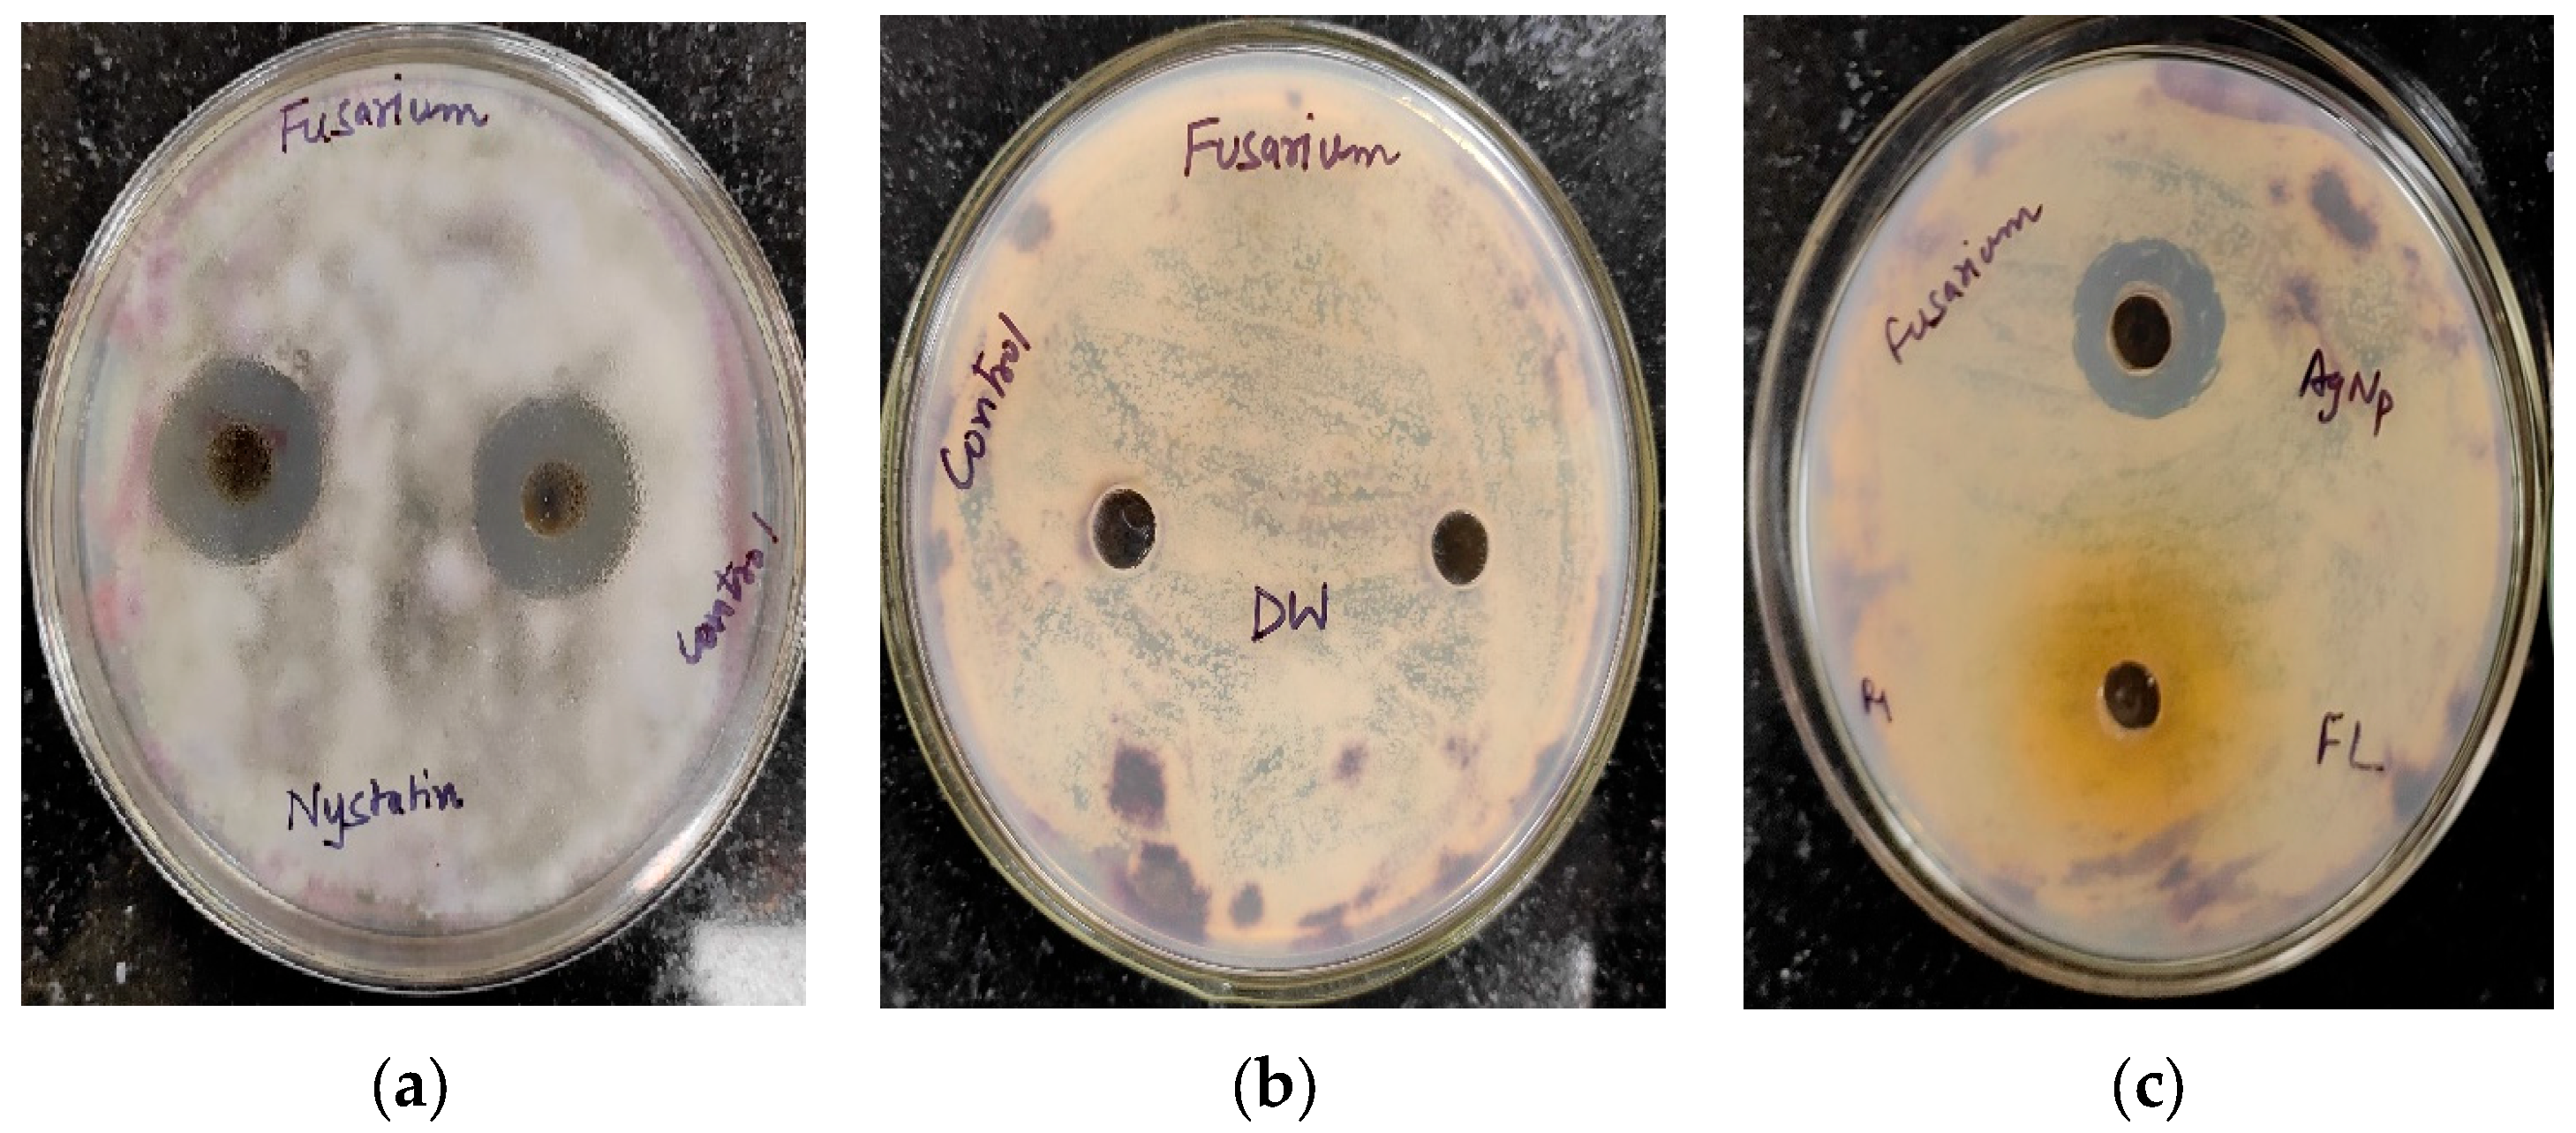

Phytofabrication of Silver Nanoparticles Using Trigonella foenum-graceum L. Leaf and Evaluation of Its Antimicrobial and Antioxidant Activities
Abstract
:1. Introduction
2. Results and Discussions
2.1. Phytochemical Analysis of Trigonella foenum-graecum L. Aqueous Leaf Extract
2.2. Biosynthesis of AgNPs
2.3. Characterization of AgNPs
2.4. Antimicrobial Activity
2.5. Antioxidant Activity
2.5.1. DPPH Free Radical Scavenging Activity
2.5.2. Total Antioxidant Capacity Using Phosphomolybdneum Assay
3. Materials and Methods
3.1. Chemicals and Collection of Plant Material
3.2. Preparation of Trigonella foenum-graecum L. aqueous Leaf Extract
3.3. Phytochemical Analysis of Trigonella foenum-graecum L. Aqueous Leaf Extract
3.3.1. Total Phenolic Content
3.3.2. Total Flavonoids
3.3.3. Total Sugars
3.3.4. Reducing Sugars
3.3.5. Non-Reducing Sugars
3.4. Biosynthesis of AgNPs
3.5. Characterization of AgNPs
3.6. Antimicrobial Activity
3.7. Antioxidant Activity
3.7.1. DPPH Free Radical Scavenging Activity
3.7.2. Total Antioxidant Capacity using Phosphomolybdneum Assay
3.8. Statistical Analysis
4. Conclusions
Author Contributions
Funding
Institutional Review Board Statement
Informed Consent Statement
Data Availability Statement
Acknowledgments
Conflicts of Interest
References
- Seid, L.; Lakhdari, D.; Berkani, M.; Belgherbi, O.; Chouder, D.; Vasseghian, Y.; Lakhdari, N. High-efficiency electrochemical degradation of phenol in aqueous solutions using Ni-PPy and Cu-PPy composite materials. J. Hazard. Mater. 2022, 423, 126986. [Google Scholar] [CrossRef]
- Singh, S.; Sangwan, S.; Sharma, P.; Devi, P.; Moond, M. Nanotechnology for sustainable agriculture: An emerging perspective. J. Nanosci. Nanotechnol. 2021, 21, 3453–3465. [Google Scholar] [CrossRef]
- Sooraj, M.P.; Nair, A.S.; Vineetha, D.J.C.P. Sunlight-mediated green synthesis of silver nanoparticles using Sidaretusa leaf extract and assessment of its antimicrobial and catalytic activities. Chem. Pap. 2021, 75, 351–363. [Google Scholar] [CrossRef]
- Thirunavoukkarasu, M.; Balaji, U.; Behera, S.; Panda, P.K.; Mishra, B.K. Biosynthesis of silver nanoparticle from leaf extract of Desmodiumgangeticum (L.) DC. and its biomedical potential. Spectrochim. Part A Mol. Biomol. Spectrosc. 2013, 1, 424–427. [Google Scholar] [CrossRef] [PubMed]
- Roy, S.; Das, T.K. Plant mediated green synthesis of silver nanoparticles-A. Int. J. Plant Biol. Res. 2015, 3, 1044–1055. [Google Scholar]
- Singh, R.P.; Magesh, S.; Rakkiyappan, C. Formation of Fenugreek (Trigonellafoenum-graecum extract mediated Ag nanoparticles: Mechanism and applications. Int. J. Bio Eng. Sci. Technol. 2011, 2, 70–80. [Google Scholar]
- Moond, M.; Singh, S.; Sangwan, S.; Devi, R.; Beniwal, R. Green Synthesis and Applications of Silver Nanoparticles: A Systematic Review. AATCC J. Res. 2022, 9, 272–285. [Google Scholar] [CrossRef]
- Devi, P.; Singh, S.; Sangwan, S.; Sihag, S.; Moond, M. Effect of pH on Phytochemical and Antioxidant Potential of Satawar Tubers (Asparagus RacemosusWilld.). J. Antioxid. Act. 2021, 2, 42–50. [Google Scholar]
- Nadagouda, M.N.; Speth, T.F.; Varma, R.S. Microwave-assisted green synthesis of silver nanostructures. Acc. Chem. Res. 2011, 44, 469–478. [Google Scholar] [CrossRef]
- Abboud, Y.; Eddahbi, A.; El Bouari, A.; Aitenneite, H.; Brouzi, K.; Mouslim, J. Microwave-assisted approach for rapid and green phytosynthesis of silver nanoparticles using aqueous onion (Allium cepa) extract and their antibacterial activity. J. Nanostructure Chem. 2013, 3, 84. [Google Scholar] [CrossRef]
- Joseph, S.; Mathew, B. Microwave assisted biosynthesis of silver nanoparticles using the rhizome extract of Alpinia galanga and evaluation of their catalytic and antimicrobial activities. J. Nanoparticles 2014, 2014, 967802. [Google Scholar] [CrossRef]
- Sumayya, A.R.; Srinivasan, S.; Amatullah, N. Screening and biochemical quantification of phytochemicals in Fenugreek (Trigonellafoenum-Graecum). Res. J. Pharm. Biol. Chem. Sci. 2012, 3, 165–169. [Google Scholar]
- Varghese, R.; Mohmmed, A.A.; Ilavenil, S.; Rebecca, J.; Choi, K.C. Silver nanoparticles synthesized using the seed extract of Trigonellafoenum-graecum L. and their antimicrobial mechanism and anticancer properties. Saudi J. Biol. Sci. 2019, 26, 148–154. [Google Scholar] [CrossRef]
- Dalal, R.; Singh, S.; Sangwan, S.; Moond, M.; Beniwal, R. Biochemical and Molecular Mechanism of Plant-mediated Synthesis of Silver Nanoparticles–A Review. Mini Rev. Org. Chem. 2022, 19, 939–954. [Google Scholar]
- Singhal, G.; Bhavesh, R.; Kasariya, K.; Sharma, A.R.; Singh, R.P. Biosynthesis of silver nanoparticles using Ocimum sanctum(Tulsi) leaf extract and screening its antimicrobial activity. J. Nanoparticle Res. 2011, 13, 2981–2988. [Google Scholar] [CrossRef]
- Samari, F.; Salehipoor, H.; Eftekhar, E.; Yousefinejad, S. Low-temperature biosynthesis of silver nanoparticles using mango leaf extract: Catalytic effect, antioxidant properties, anticancer activity and application for colorimetric sensing. New J. Chem. 2018, 42, 15905–15916. [Google Scholar] [CrossRef]
- Wani, S.A.; Kumar, P. Fenugreek: A review on its nutraceutical properties and utilization in various food products. J. Saudi Soc. Agric. Sci. 2018, 17, 97–106. [Google Scholar] [CrossRef]
- Moond, M.; Singh, S.; Sangwan, S.; Devi, P.; Beniwal, A.; Rani, J.; Kumari, A.; Rani, S. Biosynthesis of Silver Nanoparticles Utilizing Leaf Extract of Trigonella foenum-graecum L. for Catalytic Dyes Degradation and Colorimetric Sensing of Fe3+/Hg2+. Molecules 2023, 28, 951. [Google Scholar] [CrossRef]
- Trouillas, P.; Marsal, P.; Siri, D.; Lazzaroni, R.; Duroux, J.L. A DFT study of the reactivity of OH groups in quercetin and taxifolin antioxidants: The specificity of the 3-OH site. Food Chem. 2006, 97, 679–688. [Google Scholar] [CrossRef]
- Jain, S.; Mehata, M.S. Medicinal plant leaf extract and pure flavonoid mediated green synthesis of silver nanoparticles and their enhanced antibacterial property. Sci. Rep. 2017, 7, 15867. [Google Scholar] [CrossRef]
- Tomaszewska, E.; Soliwoda, K.; Kadziola, K.; Tkacz-Szczesna, B.; Celichowski, G.; Cichomski, M.; Szmaja, W.; Grobelny, J. Detection limits of DLS and UV-Vis spectroscopy in characterization of polydisperse nanoparticles colloids. J. Nanomater. 2013, 12, 404–416. [Google Scholar] [CrossRef]
- Arshad, H.; Sami, M.A.; Sadaf, S.; Hassan, U. Salvadorapersica mediated synthesis of silver nanoparticles and their antimicrobial efficacy. Sci. Rep. 2021, 11, 5996. [Google Scholar] [CrossRef] [PubMed]
- Goswami, S.R.; Sahareen, T.; Singh, M.; Kumar, S. Role of biogenic silver nanoparticles in disruption of cell–cell adhesion in Staphylococcus aureus and Escherichia coli biofilm. J. Ind. Eng. Chem. 2015, 26, 73–80. [Google Scholar] [CrossRef]
- Gopinath, V.; MubarakAli, D.; Priyadarshini, S.; Priyadharsshini, N.M.; Thajuddin, N.; Velusamy, P. Biosynthesis of silver nanoparticles from Tribulusterrestris and its antimicrobial activity: A novel biological approach. Colloids Surf. B Biointerfaces 2012, 96, 69–74. [Google Scholar] [CrossRef]
- Hernández, I.; Alegre, L.; Van Breusegem, F.; Munné-Bosch, S. How relevant are flavonoids as antioxidants in plants? Trends Plant Sci. 2009, 14, 125–132. [Google Scholar] [CrossRef]
- Singleton, V.L.; Rossi, J.A. Colorimetry of total phenolics with phosphomolybdic-phosphotungstic acid reagents. Am. J. Enol. Vitic. 1965, 16, 144–158. [Google Scholar]
- Marinova, D.; Ribarova, F.; Atanassova, M. Total Phenolics and total flavonoids in Bulgarian fruits and vegetables. J. Univ. Chem. Technol. Metall. 2005, 40, 255–260. [Google Scholar]
- Dubois, M.; Gilles, K.A.; Hamilton, J.K.; Rubers, P.A.; Smith, F. Colorimetric method for determination of sugar and related substances. Anal. Chem. 1956, 28, 350–356. [Google Scholar] [CrossRef]
- Nelson, N. A photometric adaptation of the Somogyi method for determination of glucose. J. Biol. Chem. 1944, 153, 375–380. [Google Scholar] [CrossRef]
- Hatano, T.; Kagawa, H.; Yasuhara, T.; Okuda, T. Two new flavanoids and other constituents in licorice root, their relative astringency and radical scavenging effects. Chem. Pharm. Bull. 1988, 36, 2090–2097. [Google Scholar] [CrossRef]
- Prieto, P.; Pineda, M.; Aguilar, M. Spectrophotometric quantitation of antioxidant capacity through the formation of a phosphomolybdenum complex: Specific application to the determination of vitamin E. Anal. Biochem. 1999, 269, 337–341. [Google Scholar] [CrossRef]

| Sample | Total Phenolics (mg GAE/g) | Total Flavonoids (mg CE/g) | Total Sugars (mg/g) | Reducing Sugars (mg/g) | Non-Reducing Sugars (mg/g) |
|---|---|---|---|---|---|
| Leaf extract | 8.26 ± 0.13 | 4.26 ± 0.18 | 54.48 ± 0.81 | 0.93 ± 0.01 | 53.55 ± 0.80 |
| Element | Carbon | Oxygen | Silver | Silicon | Chlorine |
|---|---|---|---|---|---|
| Weight % | 11.79 | 15.01 | 46.94 | 20.86 | 5.40 |
| Atomic % | 30.21 | 28.87 | 13.39 | 22.85 | 4.68 |
Disclaimer/Publisher’s Note: The statements, opinions and data contained in all publications are solely those of the individual author(s) and contributor(s) and not of MDPI and/or the editor(s). MDPI and/or the editor(s) disclaim responsibility for any injury to people or property resulting from any ideas, methods, instructions or products referred to in the content. |
© 2023 by the authors. Licensee MDPI, Basel, Switzerland. This article is an open access article distributed under the terms and conditions of the Creative Commons Attribution (CC BY) license (https://creativecommons.org/licenses/by/4.0/).
Share and Cite
Moond, M.; Singh, S.; Sangwan, S.; Rani, S.; Beniwal, A.; Rani, J.; Kumari, A.; Rani, I.; Devi, P. Phytofabrication of Silver Nanoparticles Using Trigonella foenum-graceum L. Leaf and Evaluation of Its Antimicrobial and Antioxidant Activities. Int. J. Mol. Sci. 2023, 24, 3480. https://doi.org/10.3390/ijms24043480
Moond M, Singh S, Sangwan S, Rani S, Beniwal A, Rani J, Kumari A, Rani I, Devi P. Phytofabrication of Silver Nanoparticles Using Trigonella foenum-graceum L. Leaf and Evaluation of Its Antimicrobial and Antioxidant Activities. International Journal of Molecular Sciences. 2023; 24(4):3480. https://doi.org/10.3390/ijms24043480
Chicago/Turabian StyleMoond, Monika, Sushila Singh, Seema Sangwan, Savita Rani, Anuradha Beniwal, Jyoti Rani, Anita Kumari, Indu Rani, and Parvesh Devi. 2023. "Phytofabrication of Silver Nanoparticles Using Trigonella foenum-graceum L. Leaf and Evaluation of Its Antimicrobial and Antioxidant Activities" International Journal of Molecular Sciences 24, no. 4: 3480. https://doi.org/10.3390/ijms24043480
APA StyleMoond, M., Singh, S., Sangwan, S., Rani, S., Beniwal, A., Rani, J., Kumari, A., Rani, I., & Devi, P. (2023). Phytofabrication of Silver Nanoparticles Using Trigonella foenum-graceum L. Leaf and Evaluation of Its Antimicrobial and Antioxidant Activities. International Journal of Molecular Sciences, 24(4), 3480. https://doi.org/10.3390/ijms24043480

